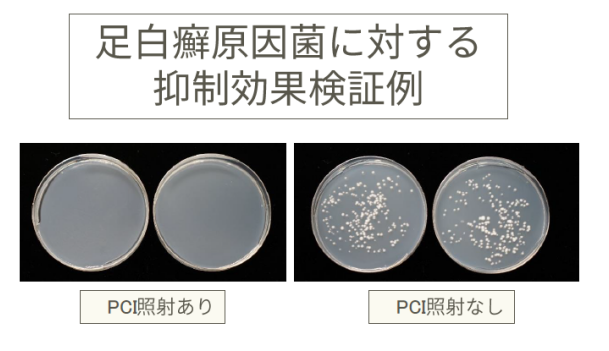

科技界的宝藏男孩 夏普黑科技PCI技术再曝新功能 5G手机已交付
科技界的宝藏男孩 夏普黑科技PCI技术再曝新功能 5G手机已交付
2019-07-02 16:37:07 来源:北国网 抢沙发
抢沙发
2019-07-02 16:37:07 来源:北国网
摘要:近日夏普一份有关新产品的资料遭到了曝光,作为以高科技为公司发展原动力的夏普,再次有多项科技成果亮相,其中以夏普白电当家核心科技PCI净离子群技术的新进展最引人瞩目。同时在目前最热门的5G领域,夏普也有最新的商用机已经向软银进行了交付等等,可以说颇具看点。
关键词:
夏普
近日夏普一份有关新产品的资料遭到了曝光,作为以高科技为公司发展原动力的夏普,再次有多项科技成果亮相,其中以夏普白电当家核心科技PCI净离子群技术的新进展最引人瞩目。同时在目前最热门的5G领域,夏普也有最新的商用机已经向软银进行了交付等等,可以说颇具看点。
夏普PCI净离子群能有效杀灭足癣病菌
作为夏普白电的看家技术,可以说集保湿杀菌除静电等等功能于一身的PCI净离子群技术,一经推出就以它强大并且直观的优异表现获得了业界和消费者的普遍认可,目前夏普已经将PCI净离子群技术应用于夏普的空气净化器、冰箱、洗衣机、吹风机以及头皮按摩仪等产品中。
夏普净离子群技术是由夏普工程师西川和男于1998年在研究空气净化技术时发现,当白血球负责攻击侵入人体的细菌、异物,在进行攻击时,白血球会释放出H+和O2-两种离子,而PCI净离子群技术的发现正是源于此。这个过程产生器释放与大自然相同的H+和O2-,H+和O2-在浮游菌的周围凝聚后,产生化学反应变成了OH氢氧根离子。
这些OH氢氧根离子从浮游菌细胞膜的蛋白质中抽取出氢,从而使霉菌、病毒丧失生物机能,而对人体无害。通过电离空气中的水分子释放正负离子,与细菌或病毒表面的羟基反应,使病菌脱水灭活,从而达到空气净化的目的。且这个净化过程产生的物质是水,十分环保无害。
而根据最新的实验数据表明,PCI净离子群技术对于足癣(脚气)有明显抑制的作用,实验证明对于90%以上足癣病患者携带的致病菌有抑制效果,确认对于银屑病菌的发芽和菌丝声张有抑制效果;确认当PCI净离子群浓度达到200000 /cm3时,对于病菌的增殖抑制有显著效果。
早前有实验数据显示,当PCI净离子群浓度达到50000/cm3时,可以让人仿佛置身于森林中一样,从而达到放松身心,提高注意力的作用,这也是现代人日常最需要的一个功能。如今PCI净离子群技术再次被证明有抑制足癣的作用,也令PCI净离子群技术的实用性再次大幅度提升。
夏普5G手机携手VR/AR亮相富士动漫节
对于目前最热门的5G技术,夏普也已经将5G智能电话交付给日本电信公司软银,并且在7月26日-28日举行的日本富士动漫节19中,通过这款5G手机可以上传和下载每个会场的舞台和观众的现场影像,并且通过VR/AR设备,让远程的观众体验身临其境的临场感。
在8月下旬,夏普也将向NTT提供5G CPE设备预订的供货。而在9月将在乐天举行5G智能手机预售。
内置全新4K引擎的新4K产品亮相
支持日本全新4K卫星广播的“BS4K.l10度CS4K双调谐器”的AQUOS 4K产品也有曝光,内置了夏普全新开发的引擎“AQUOS 4K Smart Engine PRO II”,让显示效果更加忠实于原画质的色彩表现和灰度还原,追求影像最真实的原本表现。
本次曝光的AQUOS 4K新品共有8款,分别是4T-C70/60/50/45BN1,4T-C55/50/45BL1和4T-C40BJ1,除了尺寸最大的4T-C70BN1之外,其余7款均采用了节省空间的“旋转支架”设计,也更加适合小空间环境使用。
此外,这份文件中还曝光了适合小规模企业的,小型数字全彩色复印机BP-20C25/DX-20C20,尺寸仅为560mm×560mm,并且集复印、打印、扫描和传真于一身。采用Windows系统的触摸屏幕POS机,同样在强大功能的同时缩小设备的体积,以求适用于紧凑型店面的使用诉求。还有可移动太阳能充电支架、简化税率计算的计算器以及可以训练和提高年站着脑部健康的医疗看护设备等等。
“液晶之父”和“8K之父”是现如今夏普最广为人知的标签,但是放眼夏普的品牌历史长卷中,夏普还拥有多个第一,比如全球首个自动铅笔、第一台日本国产收音机、第一台日本国产黑白显像管电视等等等等,可以说科技创新就是夏普的基因,并且现在仍然拥有大量的技术储备。
根据这份资料显示,以上产品已经率先与日本上市,相信未来在夏普会长兼社长戴正吴制定的全球一体化战略指导下,夏普可以早日将这些优秀的产品向全球市场推出,让中国消费者在内的全球用户享受到夏普黑科技所带来的便利。
第四十一届CIO班招生
国际CIO认证培训
首席数据官(CDO)认证培训
责编:liukai
免责声明:本网站(http://www.ciotimes.com/)内容主要来自原创、合作媒体供稿和第三方投稿,凡在本网站出现的信息,均仅供参考。本网站将尽力确保所提供信息的准确性及可靠性,但不保证有关资料的准确性及可靠性,读者在使用前请进一步核实,并对任何自主决定的行为负责。本网站对有关资料所引致的错误、不确或遗漏,概不负任何法律责任。
本网站刊载的所有内容(包括但不仅限文字、图片、LOGO、音频、视频、软件、程序等)版权归原作者所有。任何单位或个人认为本网站中的内容可能涉嫌侵犯其知识产权或存在不实内容时,请及时通知本站,予以删除。